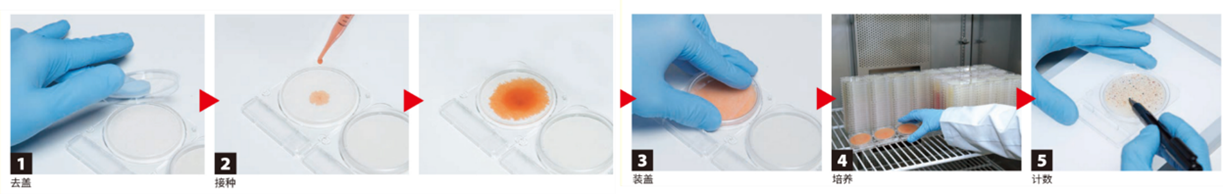

發(fā)布時間:2024-03-19 閱讀次數(shù):564次

剛剛結(jié)束的315晚會曝光了個別企業(yè)采用未經(jīng)嚴格處理的槽頭肉制作預制菜梅菜扣肉,現(xiàn)場觸目驚心。槽頭肉因為含有大量淋巴結(jié)、脂肪瘤和甲狀腺,屬于豬肉中必須進行嚴格“整修”的部分。這一事件,無疑又將預制菜推向了輿論的風口浪尖。

預制菜作為食品工業(yè)發(fā)展的必然產(chǎn)物,其發(fā)展趨勢是不可逆的。如何保障預制菜的品質(zhì)安全?島津可提供以下7個方面的解決方案。
Part 1 有毒有害類
即農(nóng)殘、獸殘、添加劑、真菌毒素等。島津的LC、GC、LC-MS/MS、GC-MS、GC-MS/MS、ICPMS能很好的應對這些項目,同時,我們也有豐富的數(shù)據(jù)庫、應用文集和解決方案提供給用戶。

圖1 T3(左,三碘甲狀腺原氨酸0.26ng/mL)、T4(右,甲狀腺素4ng/mL)MRM色譜圖(LCMS-8050)

圖2 27種性激素標液的MRM色譜圖(2ng/mL,LCMS-8045)

Part 2 營養(yǎng)物質(zhì)
部分預制菜營養(yǎng)價值低,一直被消費者所詬病。針對預制菜營養(yǎng)物質(zhì)的保留,如維生素、氨基酸、脂肪酸等,島津也有相應的儀器配置和解決案例。

圖3 島津維生素ADE二維液相系統(tǒng)

Part 3 風味
一些口味“刁鉆”的老饕,只需淺嘗一口就能區(qū)分出“現(xiàn)炒”和“預制”,這里主要是因為現(xiàn)炒的菜肴富有“鍋氣”,如何讓預制菜保留“鍋氣”,這成為預制菜的更高要求。島津的風味分析系統(tǒng)可以在此領域發(fā)揮作用。

Part 4 口感
由于預制菜通常需要二次加熱,在此過程中,食品的脆度、彈性等特性可能受到較大影響(如脆皮燒鴨、牛肉丸等),島津的質(zhì)構(gòu)儀(EZ-X)可以通過TPA、壓縮、穿刺、彎曲等試驗,測試食品的物理性能——硬度、脆度、彈性、粘附性、凝聚性等。

圖4 牛肉丸的質(zhì)構(gòu)分析

質(zhì)構(gòu)儀Texture Analyzer EZ-Test
Part 5 包裝材料
預制菜離不開各種材質(zhì)的包裝材料,包材的安全性、是否耐高溫抗高壓、包材污染物遷移問題、包材是否會影響預制菜風味,這些都是預制菜生產(chǎn)企業(yè)應該注意的問題。

圖5 食品接觸材料及制品中29種芳香族伯胺遷移量的測定


Part 6 真實性
除即配類預制菜可以通過肉眼直接看出食品原料,其他類別的預制菜則無法實現(xiàn)此目的,因此預制菜的真實性也是消費者擔心的問題之一。島津Multina可以用來鑒定食品真?zhèn)巍?/p>

圖6 10種肉類鑒定

圖7 羊奶粉、牛奶粉的鑒定
Part 7 微生物總數(shù)及種類鑒定
島津提供微生物快速測試片(通過AOAC,檢科院,Microval等權(quán)威認證)用于檢測菌落總數(shù)、大腸菌群、霉菌和酵母、金黃色葡萄球菌等。
圖1 T3(左,三碘甲狀腺原氨酸0.26ng/mL)、T4(右,甲狀腺素4ng/mL)MRM色譜圖(LCMS-8050)
島津iDplus系列MALDI-TOF微生物鑒定系統(tǒng)可供預制菜用戶進行微生物鑒定研究。

本文內(nèi)容非商業(yè)廣告,僅供專業(yè)人士參考。